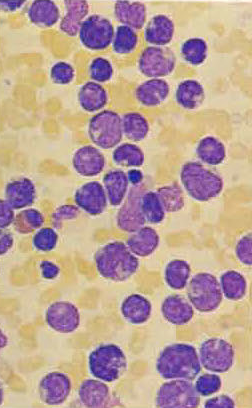

Find Russian, Spain and German Translation for Blood Smear and Urine Analyses. Please correct and send comments Thanks Rolf Neth
find your language here:
Russian, Spanish, and German Versions available published in Science Connections Wilsede
Blood Smear and Urine Status Springer Verlag) // russion version
Diagnostic indications of blood smears and urine analyses for both the guidance and treatment of patients are shown. Physicians may employ these methods for 50% of the patients at the physician’s office and for 100% of the hospital patients.
The blood smear and the urine status provide diagnostic indications to the physician and allow a fast, effective and low-cost treatment for up to 75% of the patients.
For more than 100 years (1878), medical student Paul Ehrlich „Contributions to theory and practice of histological staining“, blood smears, and for more than 1000 years (Galenus), urine analyses have been successfully used in the medical treatment of patients.
In the medical field, above all for the assessment of anemias, infections, immune system disorders, leukemias/lymphomas, malaria, aids, etc.
Blood Smear
The Blood Smear Idea
| Rolf Neth | Donald Pinkel | Andrey Vorobiov |
| UKE Hamburg | University of Texas | Russian Academy of Science, Moscow |
The visible colours between red and blue of a blood smear show the reactive changes and proliferative disturbances of blood cell functions.

The assessment of microscopic examinations of blood cells is a successful diagnostic method that is more than 100 years old and cannot be replaced by modern, expensive „click“ machines.
Blutausstrich Analyse (J Pathol Inform. 2014 Mar 28;5:9. doi: 10.4103/2153-3539.129442. eCollection 2014.)

1878: Medical student Paul Ehrlich earns his doctorate with “Contributions to theory and practice of histological staining”
The preparation of a blood smear is easy, inexpensive and does not depend on climate. Trained medical professionals are able to prepare a blood smear within 10 minutes. (3).

Preparation of a blood smear in a meandering pattern. The blood smear sample needs to be assessed microscopically.
Blood smears are used to assess anemias, infections, immune system disorders, aids, malaria and leukemias.
Excellent sample

Erythrozyten 2 Granuöozyten, 1 B-Lymphozyt, 1 T-Lymphozyt, Thrombozyten (right picture)
Poor sample

Blood smears are used to assess anemias, infections, immune system disorders, aids, malaria and leukemias.
Anemias
Hyperchromasia and anisocytosis – Vitamin B12 defency anemia |
Hypochromasia and anisocytosis - iron deficiency anemia |
![]() |
![]() |
Hypochromasia and poikilocytosis - thalassemia |
Spherocytes- hemolytic anemia |
Anisocytosis and sickle cells - sickle cell anemia |
![]() |
![]() |
![]() |
Infections
Bacterial Infections
| Deviation to the left and forms of stimuli of lymphopoesis | toxic granulocytes - sepsis |
![]() |
![]() |
Proliferation, Ausdifferenzierung und Funktion der Geanulozyten (Marcel Bessis "Blood Smears Reinterpredet Springer 1977)
Proliferation, Ausdifferenzierung und Funktion der Geanulozyten (Marcel Bessis "Blood Smears Reinterpredet Springer 1977)
Wilsede 1973

(picture - Marcel Bessis sits in the middle)
Lymphocytosis- virus infection, Aids and Ebola |
Lymphocytes - mononucleosis infectiosa |
Plasma cell - rubella |
![]() |
![]() |
![]() |
|
|
De novo Generation of Cells within Human Nurse Macrophages and Consequences following HIV-1 Infection

(A) complex colony in MDM culture. (B, C) Wright’s-Giemsa-stained, large multinucleated cells, with atypical (B) and typical (C) morphology, recovered from the adherent population of a 31-day-old MDM culture. (D-G) Responses of EDTA-recovered replated macrophages to IL-2. Macrophages were detached on D31 of culture, replated at low density, and IL-2 added 2 days later, after extensive washing. Cells were photographed on day 8 (D-F) or day 6 (G) of IL-2 exposure. Arrows in (G) point to nurse macrophages within a cell cluster. (H, I) IL-2-mediated induction of dendritic processes on replated macrophages. To aid visualization, shown here are macrophages infected with an HIV-1 strain harboring the enhanced green fluorescent protein gene. Macrophages were infected with HIV-1 pSV162R3, subjected to EDTA removal 15 days following infection, and replated. IL-2 was added 4 days later, after washing, and the treated and untreated cultures photographed on day 5. Similar responses of uninfected cells to IL-2 are shown in Fig. S1. (J, K) Nurse macrophages exhibit reduced phagocytic capabilities. Macrophage cultures were established directly from PBMC in 24-well plates. (No Il-2 was used.) To assess phagocytosis, the cells were incubated with 6 mm plastic microspheres for 24 hours, then washed to remove excess spheres and scored. For scoring, NM were identified by size, morphology and the presence of multiple nuclei. The fluorescent dye Hoechst 33342 was added to visualize cell nuclei. (J) Quantitation of microspheres per cell. Fields were selected for scoring based on the presence of NM; 100 macrophages of each type were scored per experiment. Error bars depict SEM. Similar results were obtained in two additional experiments. (K) Apparent is a large NM lacking microspheres (arrow), surrounded by several microsphere-containing macrophages. Size bars: (A) and (E) 100 µm, (B) (C) and (F) 25 µm and (G) 50 µm. Magnification: (D) and (I) x100, (H) x200 and (K) x400.
doi:10.1371/journal.pone.0040139.g001
Parasitic Diseases
Malaria
"On methylene blue and its clinical-bacterioscopic usage" - "Ueber das Methylenblau und seine klinisch-bakterioskopische Verwerthung'' - Zeitschrift für klinische Medizin 2 (1882), 710-7131891: Paul Ehrlich and Paul Guttmann use methylen blue for the treatment of malaria- first steps towards the development of chemotherapy

(„Ueber das Methylenblau und seine klinisch-bakterioskopische Verwerthung“)
| Malaria tropica | Malaria tertiana |
|
|
|
Leukemias
Acute lymphatic leukemia |
Acute undifferentiated leukemia |
|
![]() |
![]() |
|
The physician makes use of the diagnostic indication of blood cell diagnostics for the medical consultation and treatment of his/her patients.
Urine Analysis
For more than 1000 years, urine analysis is a successful diagnostic method in medicine. In the 2nd century, Claudius Galenus of Pergamum held the opinion in his theory of juices that a disease also shows in the urine. In the late Middle Ages, the urine analysis was an important diagnostic method for physicians. The matula, a bulbous glass vessel, was regarded as a status symbol.

www.archdischild.com Figure 2 Galen's physiologicol system. Courtesy of Clarenden Press .•

In only a few minutes, a urine analysis either visually or using test strips may indicate a serious illness such as kidney infections, kidney tumours, diabetes, liver diseases, etc. at a very early stage. Millions of people are protected against severe chronical diseases and expensive therapies can be avoided.

Urin Analysis Laboratory
Leukocytes in urine

Erythrocytes in urine

The blood smear and the urine status provide diagnostic indications to the physician who may then start treatment immediately and at low costs for the majority of patients (approx. 80%). More than 100 million people, mainly children and women living in Africa and Asia, are looking for a correct diagnosis and are waiting for medical attendance.
In addition to medical therapies, patients need to be instructed about prevention, hygienic behaviour and vaccination. When current special knowledge is required, for instance malaria therapies, aids prevention, cytostatics for cancer and leukemia as well as modern current genetic diagnostics, specialists and scientists need to be contacted.


Ivan Gumenuk, Laboratory of Lubech Hospital, Chernobyl
During my guest professorship in Gomel/Belarus, I became acquainted with Ivan Gumenuk (Laboratory of Lubech Hospital, Chernobyl) working in his laboratory at an emergency ward. With very simple means he was able to reach excellent diagnostic results. Missing in his and all the other laboratories were, above all, microscopes. A manufacturer in St. Petersburg together with a foundation provided 50 microscopes for emergency wards and for my lectures in Gomel and Kiev.
Bibliografie:
- Neth R. Blutbild und Urinstatus
- Mohammed EA, Mohamed MM, Far BH, Naugler C. Peripheral blood smear image analysis: A comprehensive review. J Pathol Inform. 2014 Mar 28;5:9. Bain BJ. Diagnosis from the blood smear.N Engl J Med. 2005 Aug 4;353(5):498-507. (J Pathol Inform. 2014 Mar 28;5:9. doi: 10.4103/2153-3539.129442. eCollectio
- Piro A, Tagarelli A, Tagarelli G, Lagonia P, Quattrone A. Paul Ehrlich: the Nobel Prize in physiology or medicine 1908. Int Rev Immunol. 2008 Jan-Apr;27(1-2):1-17.
- n 2014.)
- Marcell Bessiss, Bloodsmear reinterprated, Springer, 1977
- Schmalstieg FC Jr, GoldmanAS.J Med Biogr. llya llich Metchnikoff (1845-1915) and Paul Ehrlich (1854-1915): the centennial of the 1908 Nobel Prize in Physiology or Medicine.2008 May;16(2):96-103. doi: 10.1258/jmb.2008.008006.
- Melvin Greaves, Donald Pinkel, Leukemia, Science-Connections-Wilsede
- P Dunn. Galen (AD 129-200) of Pergamun: anatomist and experimental physiologist. Arch Dis Child Fetal Neonatal Ed. Sep 2003; 88(5): F441-F443.
- Urinstatus - Streifentest
- Robert Gallo, Discovery
- Axel Zander, Development of Hematology–Development of Cancer Therapy,2014
- Olaf Neth, Modern Trends in Infections and Immunology, 2012
- Donald Pinkel Ethnicity and Survival in Children with Acute Lymphoid Leukemia, Leukemia, Vol7, Supl. 2 (Link per mail)
- Andrey I. Vorobiiev, Editor in Chief of the Hematology and Transfusiology Journal
- Melvin Greaves "Infection, Immune Response and the Aetiolpgy of Childhood Leukemia", 2oo6
- Av Mitchison Sixty Years of Immunology", 2005
- Rudolf Jänisch, Temin Lecture "Nuclear Cloning, Stem Cells and Therapeutic Possibilities", 2012
- Tim Hunt "Getting in and out of Mitosis", 2008
- Special Lectures and Interviews
- De novo Generation of Cells within Human Nurse Macrophages and Consequences following HIV-1 Infection
Authors:
| Rolf Neth | Olaf Neth | Axel Zander |
| UKE Hamburg | Hospital Universitatio Sevilla |
Petrov Medical Institut, St. Petersburg |
Multimedia: wulf.neth@gmx.de IT: erik@stunkat.de
news 2015 02 18
- Log in to post comments